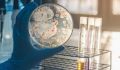
Что такое резистентность к антибиотикам? Что такое резистентность к антибиотикам?

Устойчивость к противомикробным препаратам стала одной из самых острых проблем современности, несущей биологические и экономические угрозы для всех стран. Согласно оценкам международных экспертов, устойчивость к противомикробным препаратам является причиной более 700 тысяч смертей в мире ежегодно, к 2050 году их число может вырасти до 10 миллионов. Как же предотвратить антибиотикорезистентность?
Что такое антибиотики?
Антибиотики (антибактериальные препараты) — это продукты жизнедеятельности микроорганизмов (чаще всего грибов) и их синтетические производные, которые либо вызывают гибель бактерий, либо препятствуют их росту.
Способность антибиотиков – избирательно взаимодействовать с различными структурами бактериальной клетки. Например, антибиотики могут действовать на клеточную стенку бактерий, нарушая ее проницаемость для различных веществ из-за чего бактерия погибает. Антибиотик может изменять структуру ДНК бактериальной клетки, которая является носителем наследственной информации, в том числе данных о строении бактерии. Некоторые антибиотики действуют на уровне рибосом (внутриклеточных органелл), нарушая синтез белка в клетке, что приводит к торможению процесса деления бактерий.
Каждый препарат имеет свой спектр активности, другими словами, перечень бактерий, на которые он воздействует. Потому применять антибиотики можно исключительно по назначению врача, который подберет оптимальный препарат исходя из анамнеза пациента.
Антибиотики могут быть как в форме мази или крема для местного применения, так и в форме таблетки, раствора и суспензии, которые при попадании в организм распределяются по органам и тканям, действия на возбудителей инфекций.
Важно понимать, что строение вирусов и бактерий существенно различается, поэтому антибиотики бесполезны для борьбы с вирусами.
Почему к антибиотикам развивается устойчивость?
Приспосабливаться к неблагоприятным условиям внешней среды – это естественное свойство бактерий, к которым относится и выработка устойчивости или резистентности к антибиотикам.
Любой вид бактерий может выработать устойчивость к антибиотику, особенно если он применяется часто и в большом объеме.
Эволюция бактерий проходит гораздо быстрее, чем разработка новых противомикробных препаратов, что стало серьезной угрозой для человечества, так как заболевания, вызванные резистентными к антибиотикам бактериями, протекают тяжелее и хуже поддаются лечению.
Как замедлить развитие антибиотикорезистентности?
Распространение устойчивости среди бактерий к антибиотикам — проблема сложная и многофакторная, так как данная группа препаратов очень широко используется не только в медицине, но и в сельском хозяйстве и животноводстве. При этом основной причиной все равно остается чрезмерное и неправильное применение антибиотиков при лечении различных заболеваний у человека.
Типичным примером является назначение антибиотиков при респираторных инфекциях, таких как простуда, бронхит, отит, которые в большинстве случаев вызываются вирусами, при которых антибиотики неэффективны. В то же время препараты угнетают полезные бактерии, необходимые человеку для реализации многих процессов, включая переваривание пищи, защиту от патогенных микробов и выработку гормонов. Также эти бактерии могут становиться носителями генов устойчивости и передавать их в дальнейшем другим бактериям.
Для того, чтобы сдержать развитие антибиотикорезистентности, важно соблюдать правила:
- Применять антибиотики стоит только по назначению врача.
Решение о применении противомикробных препаратов принимает врач, который исходит из жалоб пациента и результатов обследования. Самоназначение лекарств приводит лишь к усугублению заболевания, так как зачастую инфекции могут вызываться не только бактериями, но и вирусами.
- Строго следовать рекомендациям врача относительно дозировки и длительности курса лечения.
Часто люди прекращают применение антибиотиков при малейшем улучшении самочувствия или же наоборот превышают дозу и длительность курса, чтобы «уж наверняка» победить болезнь. Однако несоблюдения рекомендаций врача приведет лишь к затягиванию заболевания и развитию резистентности.
Также не стоит менять препарат на другой без указания врача, так как даже антибиотики одного класса могут воздействовать на разные виды бактерий. Особенно это касается людей с хроническими заболеваниями, применяющих другие лекарственные препараты, ведь только специалист может учесть их возможные взаимодействия и подобрать наиболее безопасный для конкретного человека антибиотик.
- Не хранить антибиотики в домашней аптечке
Хранить оставшиеся препараты в аптеке не имеет смысла, так как вероятность того, что вам назначат тот же самый антибиотик крайне мала. При этом возрастает риск приема просроченного препарата, который не только теряет эффективность, но и является токсичным для организма.
- Не давать советов по приему антибиотиков
Как неоднократно было сказано, только врач может подобрать оптимальный противомикробный препарат для конкретного случая. И даже если он помог вам, это вовсе не значит, что он поможет другому человеку. Многие заболевания имеют схожую симптоматику, но точный диагноз и необходимость применения того или иного препарата может установить только специалист.
Как преодолеть неблагоприятные последствия?
Антибиотики, как и любые другие лекарства, могут вызывать побочные эффекты, включая не только аллергические реакции, токсическое воздействие на почки и печень и т.д., но и побочные эффекты, свойственные только антибиотикам.
Современные средства отличаются хорошей переносимостью, но только при правильном применении. В подборе оптимального антибиотика и средств, снижающих побочные эффекты, для конкретного пациента может помочь только врач, что является еще одним доводом в пользу отказа от самолечения.